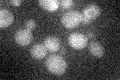
YLR321C
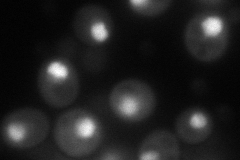
YLR321C
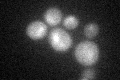
YLR321C
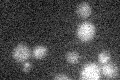
YLR321C

View description
Component of the RSC chromatin remodeling complex; essential gene required for cell cycle progression and maintenance of proper ploidy; phosphorylated in the G1 phase of the cell cycle; Snf5p paralog
Localization:
Intensity:
Fold change:
Significance:
-
C’ GFP library in SD
below threshold18.43 -
N' NOP1pr-GFP in SD
nucleolus105.248 -
N' TEF2pr-mCherry in SD

missing0 -
N' NATIVEpr-GFP in SD

missing0 -
N' TEF2pr-VC and Cyto-VN in SD

#N/A0 -
C’ GFP library in SD+DTT
cytosol15.470.83No -
C’ GFP library in SD+H2O2

cytosol16.950.91No -
C’ GFP library in Starvation Media
cytosol13.290.72No -
C’ GFP library on the background of Pup2-DaMP

below threshold -
C’ GFP library on the background of CCT mutant

below threshold18.19740.987246No
